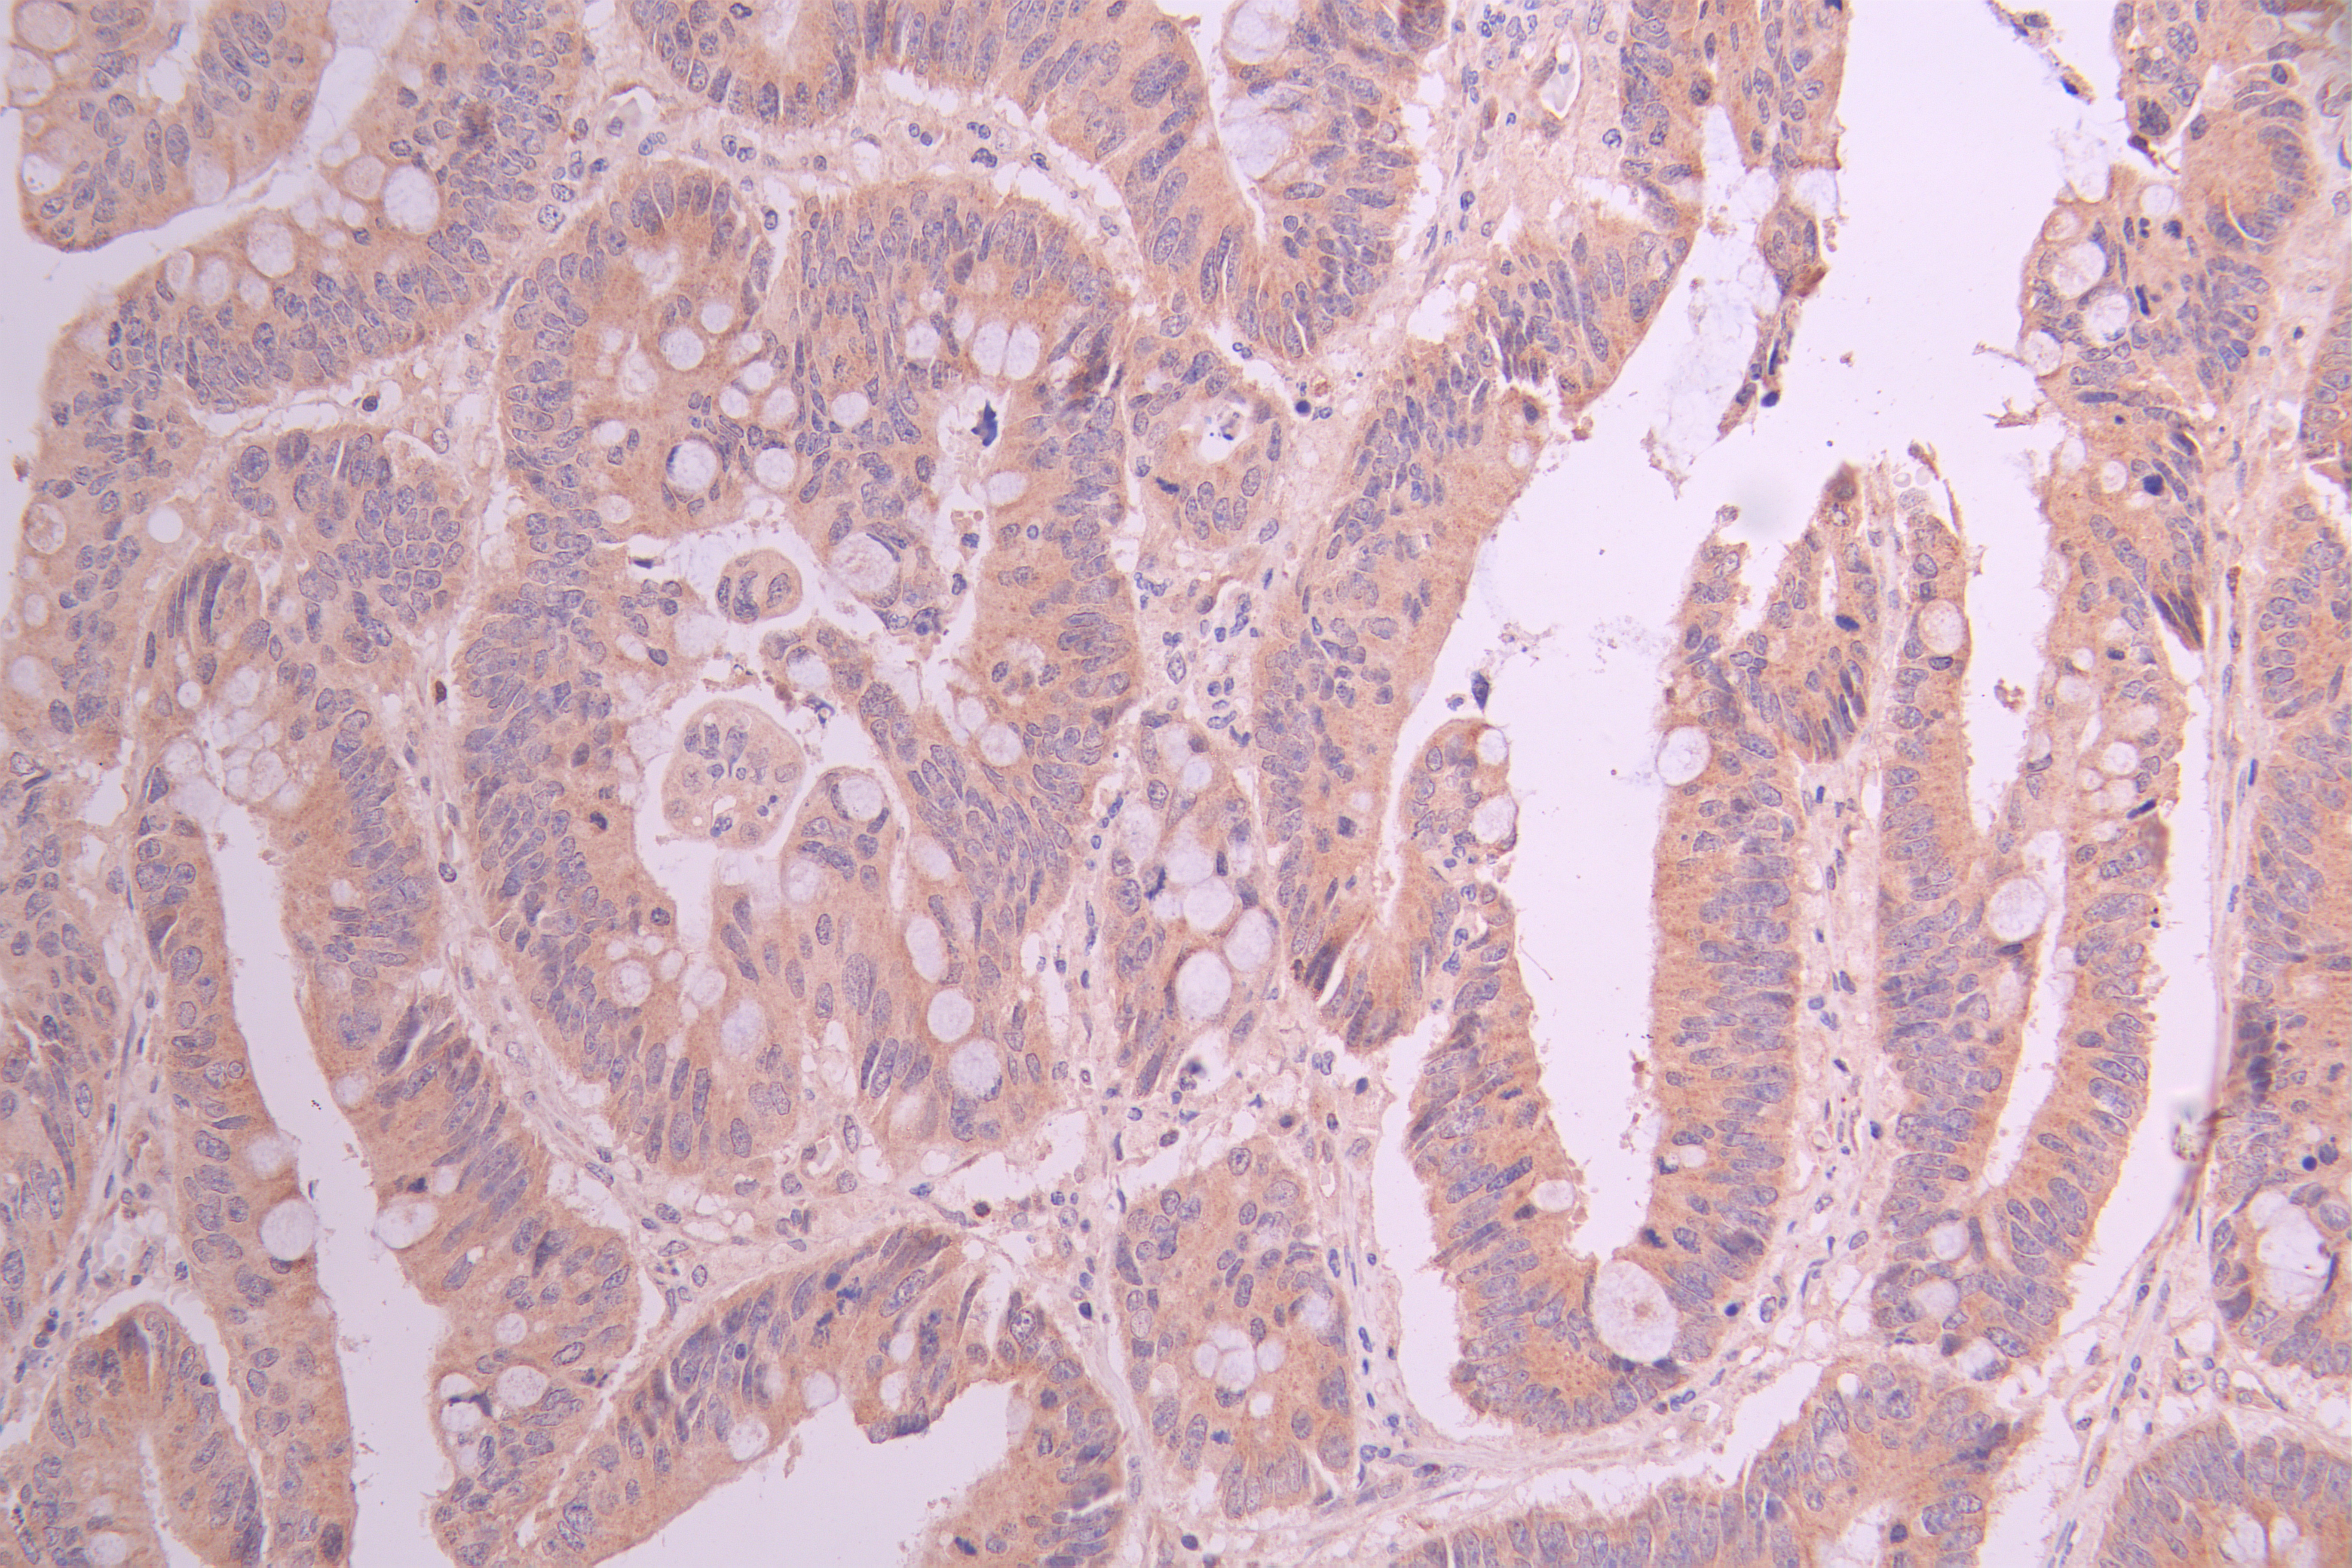

BCL2L11 Recombinant Monoclonal Antibody
-
中文名稱:BCL2L11 Recombinant Monoclonal Antibody
-
貨號(hào):CSB-RA147388A0HU
-
規(guī)格:¥1320
-
圖片:
-
Western Blot
Positive WB detected in: HepG2 whole cell lysate(30μg), U937 whole cell lysate(30μg), HEK293 whole cell lysate(30μg), HeLa whole cell lysate(30μg), COLO205 whole cell lysate(30μg)
All lanes: BCL2L11 antibody at 1:1000
Secondary
Goat polyclonal to rabbit IgG at 1/50000 dilution
Predicted band size: 22 kDa
Observed band size: 22 kDa
Exposure time: 3min -
IHC image of CSB-RA147388A0HU diluted at 1:100 and staining in paraffin-embedded human colorectal cancer performed on a Leica BondTM system. After dewaxing and hydration, antigen retrieval was mediated by high pressure in a citrate buffer (pH 6.0). Section was blocked with 10% normal goat serum 30min at RT. Then primary antibody (1% BSA) was incubated at 4°C overnight. The primary is detected by a Goat anti-rabbit polymer IgG labeled by HRP and visualized using 0.05% DAB.
-
IHC image of CSB-RA147388A0HU diluted at 1:100 and staining in paraffin-embedded human kidney tissue performed on a Leica BondTM system. After dewaxing and hydration, antigen retrieval was mediated by high pressure in a citrate buffer (pH 6.0). Section was blocked with 10% normal goat serum 30min at RT. Then primary antibody (1% BSA) was incubated at 4°C overnight. The primary is detected by a Goat anti-rabbit polymer IgG labeled by HRP and visualized using 0.05% DAB.
-
Overlay Peak curve showing jurkat cells stained with CSB-RA147388A0HU (red line) at 1:100. The cells were fixed in 4% formaldehyde and permeated by 0.2% TritonX-100 for 10min. Then 10% normal goat serum to block non-specific protein-protein interactions followed by the antibody (1ug/1*106cells) for 45min at 4℃. The secondary antibody used was FITC-conjugated goat anti-rabbit IgG (H+L) at 1/200 dilution for 35min at 4℃.Control antibody (green line) was Rabbit IgG (1ug/1*106cells) used under the same conditions. Acquisition of >10,000 events was performed.
-
-
其他:
產(chǎn)品詳情
-
Uniprot No.:
-
基因名:
-
別名:BCL2 like 11 antibody; B2L11_HUMAN antibody; BAM antibody; Bcl 2 interacting protein Bim antibody; Bcl 2 related ovarian death agonist antibody; Bcl-2-like protein 11 antibody; BCL2 interacting mediator of cell death antibody; BCL2 like 11 (apoptosis facilitator) antibody; BCL2 like protein 11 antibody; Bcl2-interacting mediator of cell death antibody; Bcl2-L-11 antibody; Bcl2l11 antibody; BIM alpha6 antibody; BIM antibody; BIM beta6 antibody; BIM beta7 antibody; BimEL antibody; BimL antibody; BOD antibody
-
反應(yīng)種屬:Human
-
免疫原:A synthesized peptide derived from human BCL2L11
-
免疫原種屬:Homo sapiens (Human)
-
標(biāo)記方式:Non-conjugated
-
克隆類型:Monoclonal
-
抗體亞型:Rabbit IgG
-
純化方式:Affinity-chromatography
-
克隆號(hào):13F3
-
濃度:It differs from different batches. Please contact us to confirm it.
-
保存緩沖液:Rabbit IgG in 10mM phosphate buffered saline , pH 7.4, 150mM sodium chloride, 0.05% BSA, 0.02% sodium azide and 50% glycerol.
-
產(chǎn)品提供形式:Liquid
-
應(yīng)用范圍:ELISA, WB, IHC, FC
-
推薦稀釋比:
Application Recommended Dilution WB 1:500-1:2000 IHC 1:50-1:200 FC 1:50-1:200 -
Protocols:
-
儲(chǔ)存條件:Upon receipt, store at -20°C or -80°C. Avoid repeated freeze.
-
貨期:Basically, we can dispatch the products out in 1-3 working days after receiving your orders. Delivery time maybe differs from different purchasing way or location, please kindly consult your local distributors for specific delivery time.
-
用途:For Research Use Only. Not for use in diagnostic or therapeutic procedures.
相關(guān)產(chǎn)品
靶點(diǎn)詳情
-
功能:Induces apoptosis and anoikis. Isoform BimL is more potent than isoform BimEL. Isoform Bim-alpha1, isoform Bim-alpha2 and isoform Bim-alpha3 induce apoptosis, although less potent than isoform BimEL, isoform BimL and isoform BimS. Isoform Bim-gamma induces apoptosis. Isoform Bim-alpha3 induces apoptosis possibly through a caspase-mediated pathway. Isoform BimAC and isoform BimABC lack the ability to induce apoptosis.
-
基因功能參考文獻(xiàn):
- POH1 knockdown induced cell apoptosis through increased expression of p53 and Bim. PMID: 29573636
- BIM deletion polymorphism was associated with significantly shorter progression-free survival (PFS) and slightly shorter overall survival (OS), compared to the WT group. Moreover, patients with BIM deletion polymorphism showed significantly inferior response to EGFR TKIs. In conclusion, our analysis confirmed that lung cancer patients harboring the BIM deletion have inferior survival and TKI responses. PMID: 30213299
- Our findings suggest that miR-23 plays a crucial role in controlling VSMCs proliferation and apoptosis by targeting BCL2L11 PMID: 30249504
- FoxO3a overexpression increased the transcription and protein expression of Bcl2like protein 11 and cyclindependent kinase inhibitor 1B, and inhibited cyclin D1 transcription and expression. PMID: 29257235
- Data indicate that miR-34a enhanced the sensitivity to cisplatin by upregulation of c-Myc and Bim pathway. PMID: 29060932
- Modulation of MEK/ERK-dependent Bim and Mcl-1 degradation critically mediates sensitivity and resistance of EGFR-mutant non-small cell lung cancer (NSCLC)cells to AZD9291 and hence is an effective strategy to overcome acquired resistance to AZD9291 PMID: 28765329
- TMEM16A expression was found to correlate with greater tumor size, less Bim expression, and less apoptotic activity overall in head and neck squamous cell carcinomas (HNSCCs). PMID: 28899969
- Hypermethylation of the proapoptotic genes BCL2 L11 and TNFRSF25 is observed in pleomorphic adenoma of the salivary glands. However, this phenomenon did not impact mRNA transcription. PMID: 28941993
- Data suggest that regulation of pancreatic beta-cell function and survival/apoptosis involves alternative splicing modulated by key splicing regulator SRP55; SRP55-regulated alternative splicing includes modulation of function of pro-apoptotic proteins (BIM, BAX), JNK signaling, and endoplasmic reticulum stress. (SRP55 = pre-mRNA-splicing factor SRP55; BAX = apoptosis regulator BAX) PMID: 29246973
- Bim expression was significantly different in the four molecular subtypes of breast cancer. PMID: 28582840
- BIM deletion is a significant predictor of shorter PFS and OS on EGFR-TKIs. Further studies to determine its effect on response to other BIM-dependent therapeutic agents are needed, so that alternative treatment strategies may be devised. PMID: 28467813
- These findings indicate the importance of developing HDAC3-selective inhibitors, and their combined use with osimertinib, for treating EGFR-mutated lung cancers carrying the BIM deletion polymorphism PMID: 27986747
- Low BIM expression is associated with renal cell carcinoma. PMID: 27582546
- The decreased miR-101-3p caused elevated Bim expression by targeting its 3'-untranslated region (3'-UTR). PMID: 28518140
- The mitochondrial apoptotic pathway, activated by BH3-only proteins, BIM and PUMA, is essential for endoplasmic reticulum stress-induced cell death; DR5 as well as caspase-8 are not required for this process. PMID: 28409774
- sequestration of Bim by Mcl-1 is a mechanism of intrinsic ABT-199 resistance and supports the clinical development of ABT-199 in combination with cytarabine or daunorubicin for the treatment of AML. PMID: 27103402
- Knock down of VDR and BIM reduces the enhancement of cell death treated with Cytarabine (AraC) followed by the addition of Doxercalciferol together with Carnosic acid (CA). PMID: 27144333
- UMI-77 enhances TRAIL-induced apoptosis by unsequestering Bim and Bak, which provides a novel therapeutic strategy for the treatment of gliomas. PMID: 28337703
- Conversion of Bim-BH3 from Activator to Inhibitor of Bak through Structure-Based Design. PMID: 29149594
- in FOXO3-death-resistant cells no point mutations in the TP53-DBD were found-in these cells FOXO3-TP53 complexes are formed and FOXO3-binding to the BIM-promoter, but not the induction of the detoxifying protein SESN3, were prevented, which in turn increased chemo-protection in this type of high-stage-derived neuroblastoma cells PMID: 28869600
- At BCL2L11, the authors identify a haematopoietic enhancer hub that is inactivated by the Epstein-Barr virus repressors EBNA3A and EBNA3C through recruitment of the H3K27 methyltransferase EZH2. PMID: 27490482
- observations suggest that an association of a deletion polymorphism of BIM and the response to induction therapy in B-cell precursor acute lymphoblastic leukemia may be clinically minimal PMID: 28641145
- expression of Bim is mediated by FoxO1 and indirectly downregulated by thyroid hormone/thyroid hormone receptor, leading to chemotherapy resistance and doxorubicin-promoted metastasis of hepatoma cells. PMID: 27490929
- BIM is associated with favorable prognostic markers for prediction of disease-free survival and overall survival in cervical cancer. PMID: 28870908
- this study shows that BIM deletion polymorphisms are associated with a poor clinical response to erlotinib and represents an independent prognostic factor for patients with EGFR positive non-small-cell lung cancer PMID: 27926478
- The Bim deletion polymorphism was found to be associated with primary resistance to crizotinib in patients with ALK fusion-positive NSCLC. PMID: 28346673
- increased apoptosis resistance was associated with significantly reduced up-regulation of proapoptotic Bim in T cells from patients with primary sclerosing cholangitis. PMID: 27630216
- Results suggest that valproic acid (VPA) reduces paraoxonase 2 (PON2) expression in glioblastoma multiforme (GBM) cells, which in turn increases reactive oxygen species (ROS) production and induces Bim protein production that inhibits cancer progression via the PON2-Bim cascade. PMID: 28108734
- Little difference in Bim expression among CD20+ cells was seen between tonsil primary follicles, tonsil germinal centers, and lupus nephritis renal tissue. The frequency of Bim-positive cells among CD4+ lymphocytes was significantly lower in lupus nephritis kidneys compared to tonsil controls. PMID: 27159593
- Inhibition of mTORC1-mediated 4EBP1 phosphorylation leads to decreased expression of c-MYC and subsequent upregulation of the proapoptotic BCL2 family member PUMA, whereas inhibition of mTORC2 results in nuclear factor-kappaB-mediated expression of the Early Growth Response 1 (EGR1) gene, which encodes a transcription factor that binds and transactivates the proapoptotic BCL2L11 locus encoding BIM. PMID: 26917778
- miR-423-3p activates oncogenic and Beclin-1-dependent autophagy and promotes GC progression by reducing the expression of Bim. The newly identified miR-423-3p-Bim axis might be a potential therapeutic target in GC. PMID: 28254439
- activation of the PI3K pathway does not suppress activation of the ARF or BIM gene by over-expressed E2F1 PMID: 27888102
- have shown that Bim protein expression in CM is an independent predictor for advanced disease confirming that this pro-apoptotic BH3-only protein might be a potent biomarker and promising therapeutic target PMID: 27356803
- BIM deletion polymorphism does not account for intrinsic resistance to EGFR-TKI in Patients With Lung Adenocarcinoma PMID: 27077907
- Mechanistically, G-Rg1 promoted the phosphorylation of Akt and FoxO3a and led to the cytoplasmic translocation of FoxO3a, which in turn suppressed FoxO3a-modulated expression of proapoptotic Bim and elevated the ratio of Bcl-2 to Bax. PMID: 27522666
- Dnd1 facilitates apoptosis by increasing the expression of Bim via its competitive combining with miR-221 in Bim-3'UTR. PMID: 28191469
- patients with BIM-g had significantly shorter progression-free survival than those without BIM-gamma (median: 304 vs. 732 days; p=0.023). CONCLUSION: Expression of BIM-gamma mRNA and BIM deletion polymorphism were strongly associated. BIM-gamma overexpression may have a role in apoptosis related to EGFR-tyrosine kinase inhibitor PMID: 27807070
- MicroRNA-301b directly targets the expression of Bim, a well-known pro-apoptotic protein. PMID: 27352910
- FOXO4 has an inhibitory effect in clearcell renal carcinoma cells, at least in part through inducing apoptosis via upregulation of Bim in the mitochondria-dependent pathway. PMID: 26780985
- Results indicate that upregulation of miR-124 could regulate apoptosis and impaired autophagy process in the MPTP model of Parkinson's disease, thus reducing the loss of dopaminergic neurons PMID: 25976060
- the Bim activated by doxorubicin-induced DNA damage might directly interrupt the interaction of Bcl-xl with pro-apoptotic proteins, Bak/Bax, to activate mitochondriadriven apoptosis. PMID: 26694174
- the BIM deletion polymorphism enhanced the emergence of populations with complete imatinib resistance, mimicking the situation in patients. PMID: 26517680
- BimEL-Bax pro-apoptotic cascade is activated by cAMP signalling of Bordetella adenylate cyclase toxin through SHP-1 phosphatase in phagocytes. PMID: 26334669
- miR-24 was found to be up-regulated while the expression of BCL2L11 was inhibited in tumor tissues of gastric cancer PMID: 26758252
- The potent antitumor activity of RHL may be mediated through downregulation of Bcl-2 and cyclin D expression and upregulation of BAX and Bim expression. PMID: 26707131
- mRNA expression of BIM and MTOR in 57 patients with EGFR-mutant non-small-cell lung cancer. PMID: 26639561
- miR-24 promotes tumor growth and angiogenesis by suppressing Bim expression in a model of pancreatic carcinoma PMID: 26517093
- miR-181b/Bim pathway may be a novel target used to overcome the chemoresistance in breast cancer PMID: 26572075
- Bcl-2 dependent NB cell lines are exquisitely sensitive to ABT-199 . Treatment with ABT-199 displaces Bim from Bcl-2 in NB to activate caspase 3, confirming the restoration of mitochondrial apoptosis PMID: 26874859
- Fluorizoline bind to prohibitin, inducing mitochondrial apoptotic pathway through NOXA and BIM upregulation. PMID: 26497683
顯示更多
收起更多
-
亞細(xì)胞定位:Endomembrane system; Peripheral membrane protein.; [Isoform BimEL]: Mitochondrion. Note=Translocates from microtubules to mitochondria on loss of cell adherence.; [Isoform BimL]: Mitochondrion.; [Isoform BimS]: Mitochondrion.; [Isoform Bim-alpha1]: Mitochondrion.
-
蛋白家族:Bcl-2 family
-
組織特異性:Isoform BimEL, isoform BimL and isoform BimS are the predominant isoforms and are widely expressed with tissue-specific variation. Isoform Bim-gamma is most abundantly expressed in small intestine and colon, and in lower levels in spleen, prostate, testis
-
數(shù)據(jù)庫(kù)鏈接:
Most popular with customers
-
-
Phospho-YAP1 (S127) Recombinant Monoclonal Antibody
Applications: ELISA, WB, IHC
Species Reactivity: Human
-
-
-
-
-
-